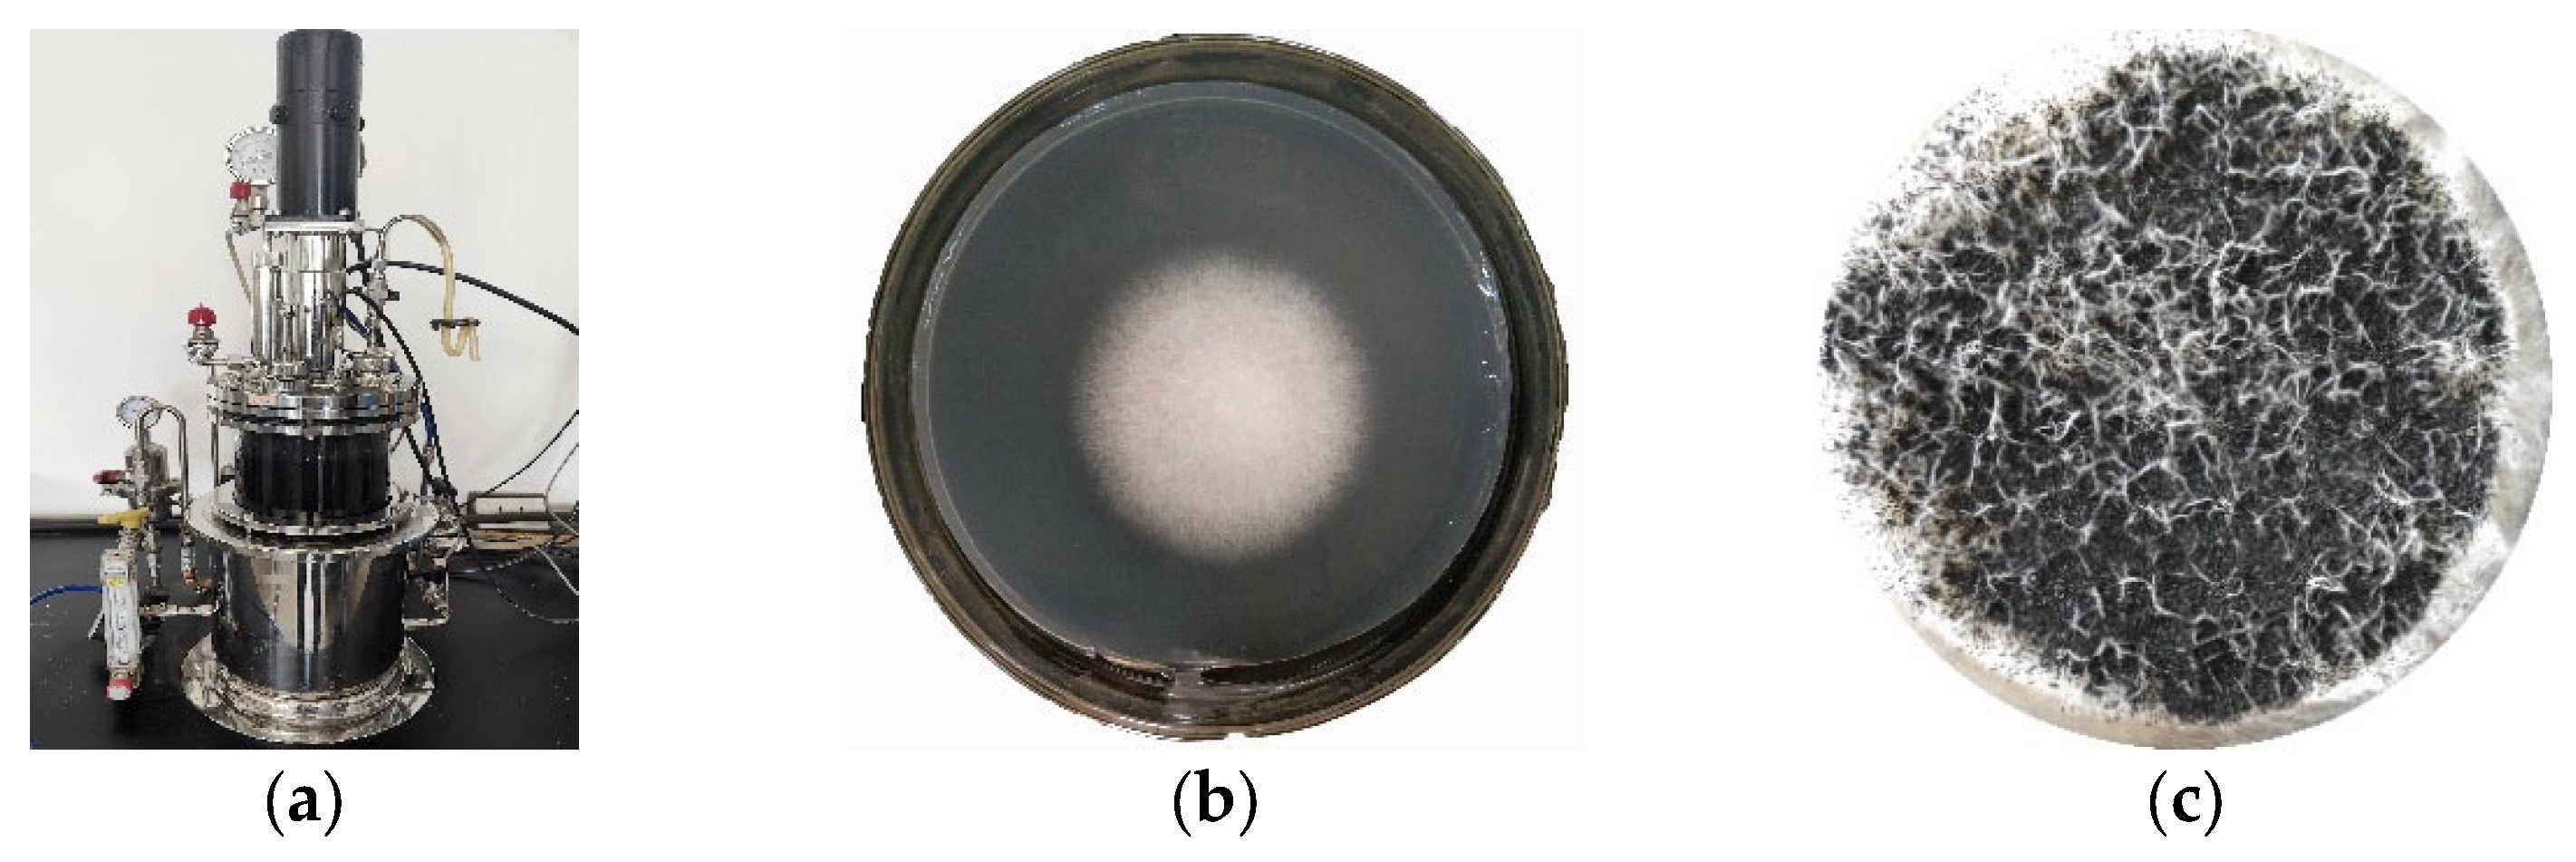
Molecules 28 05031 g012

Removal of Heavy Metal Ions from Aqueous Solution Using Biotransformed Lignite
Abstract
1. Introduction
2. Results and Discussion
2.1. Evaluation of Proximate Analysis Result of Lignite Samples
2.2. Adsorption Kinetics of BLA with Cu(II)
2.2.1. Adsorption Kinetics
2.2.2. Adsorption Isotherms
2.3. Factors Affecting Adsorption
2.3.1. Effect of Particle Size Distribution on Adsorption
2.3.2. Effect of pH
2.4. Adsorption of Four Heavy Metal Ions
2.5. Morphology and Composition of the BLA
2.6. FTIR Analysis and Molecular Mechanism of Adsorption Cu(II)
3. Materials and Methods
3.1. Material, Chemicals, and Equipment
3.2. Preparation of Biotransformed-Lignite Adsorbents (BLAs)
3.3. Adsorption Experiments
3.4. Adsorption Kinetics and Isotherm Model
3.4.1. Determination of the Adsorption Kinetics
3.4.2. Determination of the Adsorption Isotherm
- RL > 1—Unfavorable adsorption;
- RL = 1—Linear adsorption;
- 0 < RL < 1—Favorable adsorption;
- RL = 0—Irreversible adsorption.
3.5. Characterization Techniques
4. Conclusions
Author Contributions
Funding
Institutional Review Board Statement
Informed Consent Statement
Data Availability Statement
Conflicts of Interest
Sample Availability
References
- Charvalas, G.; Solomou, A.D.; Giannoulis, K.D.; Skoufogianni, E.; Bartzialis, D.; Emmanouil, C.; Danalatos, N.G. Determination of heavy metals in the territory of contaminated areas of Greece and their restoration through hyperaccumulators. Environ. Sci. Pollut. Res. 2021, 28, 3858–3863. [Google Scholar] [CrossRef] [PubMed]
- Wang, S.; Wu, W.; Liu, F. Assessment of the human health risks of heavy metals in nine typical areas. Environ. Sci. Pollut. Res. 2019, 26, 12311–12323. [Google Scholar] [CrossRef] [PubMed]
- Mohan, D.; Chander, S. Removal and recovery of metal ions from acid mine drainage using lignite—A low cost sorbent. J. Hazard. Mater. 2006, 137, 1545–1553. [Google Scholar] [CrossRef] [PubMed]
- Ali, A.; Guo, D.; Mahar, A.; Wang, P.; Ma, F.; Shen, F.; Li, R.; Zhang, Z. Phytoextraction of toxic trace elements by Sorghum bicolor inoculated with Streptomyces pactum (Act12) in contaminated soils. Ecotoxicol. Environ. Saf. 2017, 139, 202–209. [Google Scholar] [CrossRef] [PubMed]
- Munir, M.A.M.; Irshad, S.; Yousaf, B.; Muhammad, U.A.; Dan, D.; Abbas, Q.; Liu, G.J.; Yang, X.E. Interactive assessment of lignite and bamboo-biochar for geochemical speciation, modulation and uptake of Cu and other heavy metals in the copper mine tailing. Sci. Total Environ. 2021, 779, 146536. [Google Scholar] [CrossRef]
- Ezeokonkwo, M.A.; Ofor, O.F.; Ani, J.U. Preparation and evaluation of adsorbents from coal and irvingia gabonensis seed shell for the removal of Cd(II) and Pb(II) Ions from aqueous solutions. Front. Chem. 2008, 5, 132. [Google Scholar] [CrossRef]
- Jochova, M.; Punocha, M.; Horacek, J.; Stamberg, K.; Vopalka, D. Removal of heavy metals from water by lignite-based sorbents. Fuel 2004, 83, 1197–1203. [Google Scholar] [CrossRef]
- Doskoil, L.; Peka, M. Removal of metal ions from multi-component mixture using natural lignite. Fuel Process. Technol. 2012, 101, 29–34. [Google Scholar] [CrossRef]
- Di, J.; Ruan, Z.; Zhang, S.; Dong, Y.; Fu, S.; Li, H.; Jiang, G. Adsorption behaviors and mechanisms of Cu2+, Zn2+ and Pb2+ by magnetically modified lignite. Sci. Rep. 2022, 12, 1394. [Google Scholar] [CrossRef]
- Ramrakhiani, L.; Ghosh, S.; Majumdar, S. Heavy metal recovery from electroplating effluent using adsorption by jute waste-derived biochar for soil amendment and plant micro-fertilizer. Clean Technol. Environ. 2022, 24, 1261–1284. [Google Scholar] [CrossRef]
- Pentari, D.; Vamvouka, D. Cadmium removal from aqueous solutions using nano-iron doped lignite. Earth Environ. Sci. 2019, 211, 012135. [Google Scholar] [CrossRef]
- Pehlivan, E.; Arslan, G. Comparison of adsorption capacity of young brown coals and humic acids prepared from different coal mines in Anatolia. J. Hazard. Mater. 2006, 138, 401–408. [Google Scholar] [CrossRef]
- Murakami, K.; Yamada, T.; Fuda, K. Selectivity in cation exchange property of heat-treated brown coals. Fuel 2001, 80, 599–605. [Google Scholar] [CrossRef]
- Yuliani, G.; Qi, Y.; Hoadley, A.F.A.; Chaffee, A.L.; Garnier, G. Lignite clean up of magnesium bisulphite pulp mill effluent as a proxy for aqueous discharge from a ligno-cellulosic biorefinery. Biomass Bioenergy 2012, 36, 411–418. [Google Scholar] [CrossRef]
- Havelcova, M.; Mizera, J.; Sykorova, I.; Pekar, M. Sorption of metal ions on lignite and the derived humic substances. J. Hazard. Mater. 2009, 161, 559–564. [Google Scholar] [CrossRef]
- Allen, S.J.; Brown, P.A. Isotherm analyses for single component and multi-component metal sorption onto lignite. J. Chem. Technol. Biotechnol. 1995, 62, 17–24. [Google Scholar] [CrossRef]
- Pehlivan, E.; Arslan, G. Removal of metal ions using lignite in aqueous solution—Low cost biosorbents. Fuel Process. Technol. 2007, 88, 99–106. [Google Scholar] [CrossRef]
- Munir, M.A.M.; Liu, G.; Yousaf, B.; Ali, M.U.; Abbas, Q.; Ullah, H. Synergistic effects of biochar and processed fly ash on bioavailability, transformation and accumulation of heavy metals by maize (Zea mays L.) in coal-mining contaminated soil. Chemosphere 2020, 240, 124845. [Google Scholar] [CrossRef]
- Karabulut, S.; Karabakan, A.; Denizli, A.; Yurum, Y. Batch removal of copper(II) and zinc(II) from aqueous solutions with low-rank Turkish coal. Sep. Purif. Technol. 2000, 18, 177–184. [Google Scholar] [CrossRef]
- Uçurum, M. A study of removal of Pb heavy metal ions from aqueous solution using lignite and a new cheap adsorbent (lignite washing plant tailings). Fuel 2009, 88, 1460–1465. [Google Scholar] [CrossRef]
- Milicevic, S.; Boljanac, T.; Martinovic, S.; Vlahovic, M.; Milosevic, V.; Babic, B. Removal of copper from aqueous solutions by low cost adsorbent-Kolubara lignite. Fuel Process. Technol. 2012, 95, 1–7. [Google Scholar] [CrossRef]
- Miao, Z.; Pei, Z.; Gao, M.; Wan, K.; He, Q. Exploring a new way to generate mesopores in lignite by employing steam explosion. Energy Source Part A 2021, 44, 600–610. [Google Scholar] [CrossRef]
- Sakthivel, A.; Thangagiri, B.; Jeyasubramanian, K.; Raja, J.D.; Prabhahar, R.S.S.; Nayagi, S.P.B.; Krishnamurthy, N. Switching the hydrophobic Neyveli lignite into hydrophilic type by surface modification and its subsequent use for removing Cr(VI)/F from artificial pollutant. Fuel 2021, 298, 120787. [Google Scholar] [CrossRef]
- Jin, Y.; Liu, Z.; Han, L.; Zhang, Y.; Li, L.; Zhu, S.; Peng, Z.; Li, J.; Wang, D. Synthesis of coal-analcime composite from coal gangue and its adsorption performance on heavy metal ions—ScienceDirect. J. Hazard. Mater. 2022, 423, 127027. [Google Scholar] [CrossRef] [PubMed]
- Zhang, J.; Zhao, Y.; Wang, F.; Hua, D. Immobilization and remediation of Pb contaminated soil treated with bentonite, lignite and their mixed addition. Ecol. Environ. Sci. China 2019, 28, 395–402. [Google Scholar]
- Beksissa, R.; Tekola, B.; Ayala, T.; Dame, B. Investigation of the adsorption performance of acid treated lignite coal for Cr (VI) removal from aqueous solution. Environ. Chall. 2021, 4, 100091. [Google Scholar] [CrossRef]
- Jellali, S.; Azzaz, A.A.; Jeguirim, M.; Hamdi, H.; Mlayah, A. Use of lignite as a low-cost Material for cadmium and copper removal from aqueous solutions: Assessment of adsorption characteristics and exploration of involved mechanisms. Water 2021, 13, 164. [Google Scholar] [CrossRef]
- Pentari, D.; Perdikatsis, V.; Katsimicha, D.; Kanaki, A. Sorption properties of low calorific value Greek lignites: Removal of lead, cadmium, zinc and copper ions from aqueous solutions. J. Hazard. Mater. 2009, 168, 1017–1021. [Google Scholar] [CrossRef]
- Vavouraki, A.; Bartzas, G.; Komnitsas, K. Synthesis of zeolites from Greek Fly Ash and assessment of their copper removal capacity. Minerals 2020, 10, 844. [Google Scholar] [CrossRef]
- Kocaoba, S.; Orhan, Y.; Akyüz, T. Kinetics and equilibrium studies of heavy metal ions removalby use of natural zeolite. Desalination 2007, 214, 1–10. [Google Scholar] [CrossRef]
- Hameed, B.H. Equilibrium and kinetic studies of methyl violet sorption by agricultural waste. J. Hazard. Mater. 2008, 154, 204–212. [Google Scholar] [CrossRef]
- Dada, A.O.; Olalekan, A.; Olatunya, A.M.; Dada, O. Langmuir, Freundlich, Temkin and Dubinin–Radushkevich isotherms studies of equilibrium sorption of Zn(II) unto phosphoric acid modified rice husk. IOSR. J. Appl. Chem. 2012, 3, 38–45. [Google Scholar] [CrossRef]
- Demirbas, E.; Dizge, N.; Sulak, M.T.; Kobya, M. Adsorption kinetics and equilibrium of copper from aqueous solutions using hazelnut shell activated carbon. Chemi. Eng. J. 2009, 148, 480–487. [Google Scholar] [CrossRef]
- Qi, Y.; Hoadley, A.F.; Chaffee, A.L.; Garnier, G. Characterisation of lignite as an industrial adsorbent. Fuel 2011, 90, 1567–1574. [Google Scholar] [CrossRef]
- Shi, K.; Jian, L.; Kong, D.; Xiao, L. FTIR analysis of liquefaction product of long flame coal by white-rot fungi. In AER-Advances in Engineering Research; Kim, Y.H., Ed.; Atlantis Press: Amsterdam, The Netherlands, 2016; Volume 78, pp. 32–36. [Google Scholar]
- Samsuri, A.W.; Sadegh-Zadeh, F.; Seh-Bardan, B.J. Characterization of biochars produced from oil palm and rice husks and their adsorption capacities for heavy metals. Int. J. Environ. Sci. Technol. 2014, 11, 967–976. [Google Scholar] [CrossRef]
- Dong, L.; Pan, S.; Wang, Z.; Hou, L.; Zhou, G.; Chen, G. Lignite-activated carbon grafted PAA combined with conventional drinking water treatment processes for the emergency removal of trace Pb(II) pollution. Water Air Soil Pollut. 2020, 231, 230. [Google Scholar] [CrossRef]
- Yang, T.; Hodson, M.E. Investigating the potential of synthetic humic-like acid to remove metal ions from contaminated water. Sci. Total Environ. 2018, 635, 1036–1046. [Google Scholar] [CrossRef]
- Wang, P.; Ding, F.; Huang, Z.; Fu, Z.; Zhao, P.; Men, S. Adsorption behavior and mechanism of Cd(II) by modified coal-based humin. Environ. Technol. Innov. 2021, 23, 101699. [Google Scholar] [CrossRef]
- Wender, I. Catalytic synthesis of chemicals from coal. Catal. Rev. 1976, 14, 97–129. [Google Scholar] [CrossRef]
- Akimbekov, N.; Digel, I.; Qiao, X.; Tastambek, K.; Zhubanova, A. Lignite biosolubilization by Bacillus sp. RKB 2 and characterization of its products. Geomicrobiol. J. 2020, 37, 255–261. [Google Scholar] [CrossRef]
- Sezen, S.; Medine, G.; Karadayi, M.; Alaylar, B. First report of fungal strains from Afin–Elbistan mine for microbial lignite process. Geomicrobiol. J. 2020, 37, 143–146. [Google Scholar] [CrossRef]
- Kang, H.; Liu, X.; Zhang, Y.; Zhao, S.; Yang, Z.; Du, Z.; Zhou, A. Bacteria solubilization of shenmu lignite: Influence of surfactants and characterization of the biosolubilization products. Energy Source Part A 2021, 43, 1162–1180. [Google Scholar] [CrossRef]
- Ho, Y.S. Citation review of Lagergren kinetic rate equation on adsorption reactions. Scientometrics 2004, 59, 171–177. [Google Scholar]
- Du, A.; Cao, L.; Zhang, R.; Pan, R. Effects of a copper-resistant fungus on copper adsorption and chemical forms in soils. Water Air Soil Pollut. 2009, 201, 99–107. [Google Scholar] [CrossRef]
- Oguz, E. Adsorption characteristics and the kinetics of the Cr(VI) on the Thuja oriantalis. Colloid Surf. A 2005, 252, 121–128. [Google Scholar] [CrossRef]
- Ho, Y.S. Review of second-order models for asorption systems. J. Hazard. Mater. 2006, 136, 681–689. [Google Scholar] [CrossRef]
- Li, J.; Liu, X.; Yue, Z.; Zhang, Y. Biodegradation of photo-oxidized lignite and characterization of the products. Earth Environ. Sci. 2018, 108, 042122. [Google Scholar] [CrossRef]
- Li, Z.; Ni, G.; Wang, H.; Sun, Q.; Wang, G.; Jiang, B.; Zhang, C. Molecular structure characterization of lignite treated with ionic liquid via FTIR and XRD spectroscopy. Fuel 2020, 272, 117705. [Google Scholar] [CrossRef]
- Niu, C.; Xia, W. Effect of low-temperature pyrolysis on the surface hydrophobicity of low rank coal and the analysis of floatability of semi-coke. J. China Coal Soc. 2018, 43, 1423–1431. [Google Scholar] [CrossRef]

| Chemical Properties | Experimental Results | |
|---|---|---|
| Raw Lignite | BLA | |
| C (%) a | 72.32 ± 1.36 | 64.63 ± 2.17 |
| H (%) a | 4.87 ± 0.46 | 6.23 ± 0.81 |
| O *(%) a | 20.43 ± 0.32 | 25.74 ± 1.02 |
| N (%) a | 1.46 ± 0.15 | 1.97 ± 0.10 |
| S (%) a | 0.92 ± 0.08 | 0.53 ± 0.11 |
| Mad (%) | 11.63 ± 0.93 | 9.75 ± 0.71 |
| Aad (%) | 15.41 ± 0.54 | 15.12 ± 1.19 |
| Vad (%) | 38.77 ± 1.27 | 33.63 ± 0.61 |
| FC *ad (%) | 34.19 ± 0.69 | 41.50 ± 1.26 |
| BET (m2·g−1) | 1.81 ± 0.32 | 5.66 ± 0.83 |
| Pseudo-First-Order | Pseudo-Second-Order | ||||||
|---|---|---|---|---|---|---|---|
| Cu(II) (mg·L−1) | Qeexp (mg·g−1) | k1 (min−1) | qe1 (mg·g−1) | R12 | k2 (g·mg−1·min−1) | qe2 (mg·g−1) | R22 |
| 50 | 11.48 | 0.107 | 11.3 | 0.950 | 0.181 | 11.5 | 0.991 |
| 150 | 27.5 | 0.037 | 28.2 | 0.932 | 0.032 | 27.5 | 0.976 |
| 300 | 56.1 | 0.033 | 56.4 | 0.927 | 0.013 | 56.0 | 0.977 |
| 500 | 64.5 | 0.042 | 61.7 | 0.981 | 0.0092 | 64.4 | 0.992 |
| 800 | 65.0 | 0.025 | 68.4 | 0.911 | 0.0097 | 66.3 | 0.982 |
| Langmuir Isotherm | Freundlich Isotherm | ||||||
|---|---|---|---|---|---|---|---|
| Metal Ion | Qm (mg·g−1) | KL (L·mg−1) | RL | R2 | K (mg·g·L1/n·mg1/n) | n | R2 |
| Cu(II) | 71.47 | 0.00649 | 0.10–0.88 | 0.95 | 3.52 | 2.31 | 0.91 |
| Sample | Particle Size Distribution (μm) | BET Specific Surface Area (m2/g) | Cumulative Pore Volume (cm3/g) | Average Pore Diameter (nm) |
|---|---|---|---|---|
| 1 | 1000 > Φ > 825 | 7.66 | 0.06 | 24.08 |
| 2 | 825 > Φ > 425 | 6.35 | 0.05 | 23.70 |
| 3 | 425 > Φ > 250 | 6.12 | 0.04 | 22.61 |
| 4 | 225 > Φ > 150 | 5.76 | 0.04 | 19.64 |
| 5 | 150 > Φ | 3.46 | 0.01 | 5.41 |
Disclaimer/Publisher’s Note: The statements, opinions and data contained in all publications are solely those of the individual author(s) and contributor(s) and not of MDPI and/or the editor(s). MDPI and/or the editor(s) disclaim responsibility for any injury to people or property resulting from any ideas, methods, instructions or products referred to in the content. |
© 2023 by the authors. Licensee MDPI, Basel, Switzerland. This article is an open access article distributed under the terms and conditions of the Creative Commons Attribution (CC BY) license (https://creativecommons.org/licenses/by/4.0/).
Share and Cite
Cheng, J.; Zhang, S.; Fang, C.; Ma, L.; Duan, J.; Fang, X.; Li, R. Removal of Heavy Metal Ions from Aqueous Solution Using Biotransformed Lignite. Molecules 2023, 28, 5031. https://doi.org/10.3390/molecules28135031
Cheng J, Zhang S, Fang C, Ma L, Duan J, Fang X, Li R. Removal of Heavy Metal Ions from Aqueous Solution Using Biotransformed Lignite. Molecules. 2023; 28(13):5031. https://doi.org/10.3390/molecules28135031
Chicago/Turabian StyleCheng, Jianguo, Shanfei Zhang, Chen Fang, Litong Ma, Jianguo Duan, Xu Fang, and Rihong Li. 2023. "Removal of Heavy Metal Ions from Aqueous Solution Using Biotransformed Lignite" Molecules 28, no. 13: 5031. https://doi.org/10.3390/molecules28135031
APA StyleCheng, J., Zhang, S., Fang, C., Ma, L., Duan, J., Fang, X., & Li, R. (2023). Removal of Heavy Metal Ions from Aqueous Solution Using Biotransformed Lignite. Molecules, 28(13), 5031. https://doi.org/10.3390/molecules28135031

